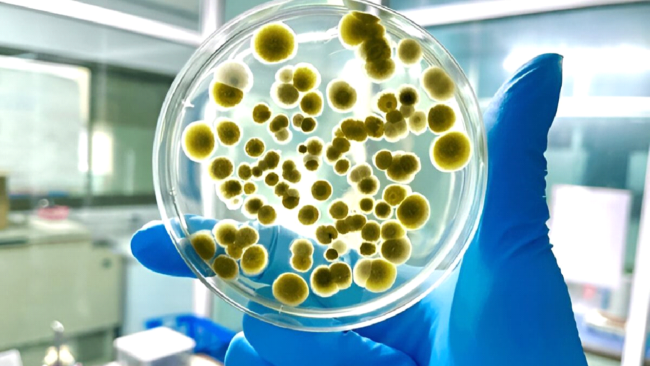

Mold is dangerous for health. It can lead to severe health conditions, especially for those with asthma or allergies. It can even lead to structural damage to your property if left untreated. Mold testing is a must when it comes to the safety of your home and your loved ones. If you suspect mold in your home, it is important to act quickly and seek professional help to address the issue before it worsens. Let’s discuss the types of mold, their dangerous effects, and how to eliminate them.
What is Mold?
Mold is a fungi-like organism that is naturally present in the environment. It is likely found where moisture and oxygen are used outside, and it plays an integral part in maintaining ecosystems. However, its presence indoors can become problematic. Mold can cause dangerous health problems, such as allergies and infections. Knowing about its symptoms and their dangers is essential to making your space free of mold.
Importance of Understanding Different Types of Mold
Understanding different types of mold is crucial for maintaining a healthy indoor environment. Some types of mold do not cause any harm; others can cause allergies, long-term illness, and respiratory problems. Identifying different types of mold helps in determining the right remediation approach to be taken. Hence, it is important to understand the different types of mold and their symptoms.
Common Types of Mold
You will likely find mold growth in the most profound, dampest spaces of your building. Mold growth is a pressing issue in Southern cities, especially in San Diego, San Bernardino, and Los Angeles. The most common causes are humidity, water damage, or poor ventilation. Here are some common mold types.
1. Stachybotrys Chartarum
Stachybotrys Chartarum, or Toxic Black Mold, looks like black or dark green spots or patches, producing a musty smell. It is found in moist areas like ceilings, carpets, and water-damaged walls. The mold creates mycotoxins and can cause serious health problems.
- Coughing and wheezing
- Chronic respiratory and breathing problems
- Headaches, nausea, and dizziness
- Allergic reactions
2. Aspergillus
Aspergillus is a common indoor mold. Its spores are of various colors, such as yellow, green, or brown. It most commonly appears in insulation, air conditioning systems, and walls. People with weak immune systems suffer the most from it because it causes severe lung infections.
- Lung infections
- Sinus issues
- Allergies such as skin irritation and sneezing
- Aspergillosis
3. Cladosporium
It is a mold that can grow in hot and cold environments. Its color is usually dark green or black. Cladosporium is most commonly found in fabrics, wood, and HVAC systems.
- Skin and eye allergies
- Sinus infections
- Asthma problem
4. Penicillium
Penicillium is triggered by water damage and grows rapidly in water-damaged properties. It is blue-green and most likely a powder. It spreads through porous materials such as carpets, wallpapers, insulation, and wood.
- Respiratory infections
- Chronic congestion issues
- Sinus problems
- Allergies
5. Alternaria
Alternaria is a fast-growing mold with a dark green or brown color and a velvety texture. It appears in patches on any surface and is found in damp areas such as basements, showers, etc.
- Severe Asthma
- Sneezing and irritation in the nose
- Wheezing
- Skin irritation
Symptoms of Mold Exposure
Different types of mold have the potential to cause dangerous and irritating health problems. Living in a place where you inhale mold or touch it can result in symptoms such as:
- Eye irritation
- Wheezing
- Coughing
- Sinus infections
- Congestion and runny nose
- Skin rash
- Sore throat
- Respiratory issues
- Lung irritation
- Headaches
- Nausea or dizziness
If mold is present in your home and you have health problems, consult a doctor. While it’s not an emergency for most people, letting your doctor know reduces the risk of potential complications.
How Dangerous is Mold?
Mold infestations produce serious dangers that harm both human health and structural integrity. The degree of risk of mold exposure depends on the type and duration of exposure and a person’s health condition.

Dangerous Health Issues
Some molds, such as Stachybotrys Chartarumm, cause chronic respiratory issues that can lead to organ damage. Some cases even involve neurological disorders. Moreover, long-term exposure can harm infants and older adults.
Structural Damage
Mold affects household structures made of wood, insulation, and drywall. If the mold-affected area is not treated for a long time, it can weaken flooring, walls, and ceilings, making repairs costly.
Treatment of Mold Infested Areas
Professional mold remediation companies use advanced treatment methods and technologies to treat mold-infested areas.
Inspecting the Mold-Covered Space
The first step is to inspect the area to determine the source and extent of the infestation. This involves using moisture meters, air sample collectors, and thermal imaging sensors.
Air Filtration
Mold spores spread in the air, causing health problems. Containment barriers and HEPA-filtered negative air machines are used to filter the air.
Mold Removal
It must be removed entirely if mold has infested carpets, insulation, and drywall. Antimicrobial treatments and HEPA vacuums are used to remove mold.
Dehumidifying the Area
Dehumidifiers and air movers remove excess moisture from the area, preventing mold from returning.
Post Remediation Test
Air quality tests are done after removing the mold to make sure the place is safe from mold. This makes the place completely free from contaminants.
How To Prevent Mold Growth?
Following are some steps that you can take to prevent different types of mold growth.
- If a leak appears in the roof, pipes, or walls, fix it immediately.
- Improve the ventilation system so there is no moisture inside the building.
- Make sure indoor humidity is controlled.
- If an area gets wet, like in the washroom or kitchen, dry the area quickly.
- Use mold-resistant paints and drywalls to prevent mold.
Schedule an Inspection
Mold is not just an unsightly nuisance – it’s a serious health problem that requires attention. If you suspect mold growth in your home or business, don’t wait for the issue to worsen. Call a professional mold remediation company for a thorough inspection and consultation. Let their experts restore your property to a safe, mold-free environment.
